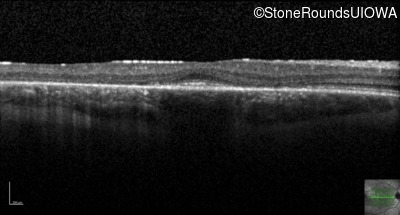
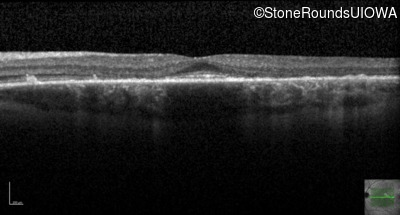
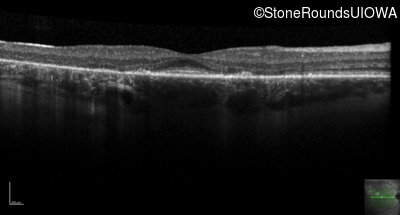
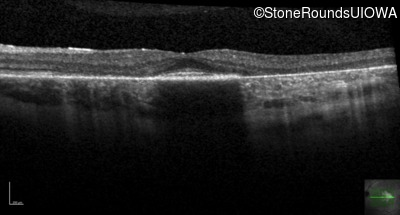
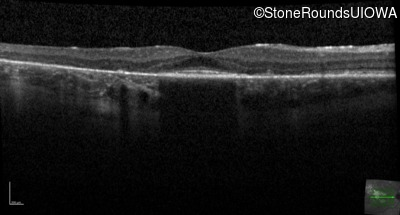
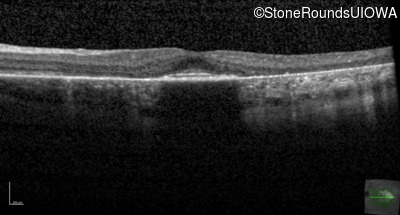
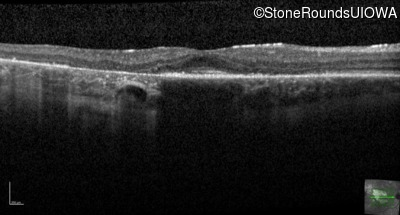
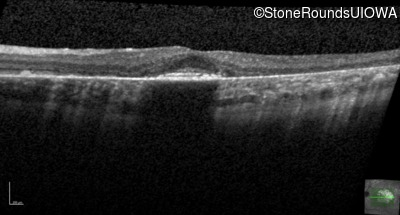
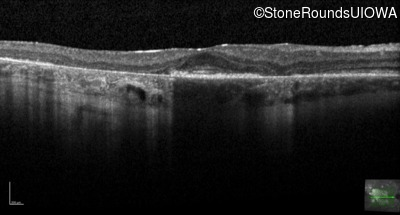
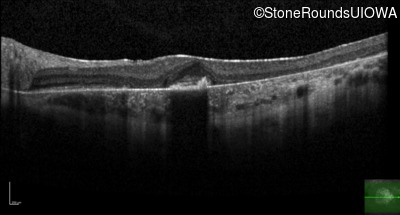
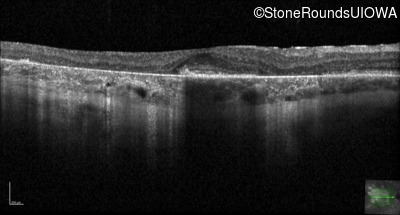
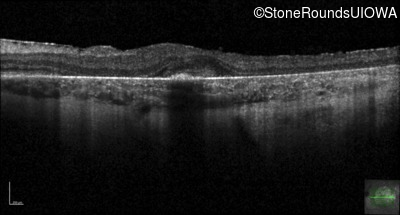
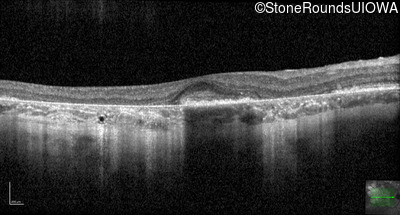
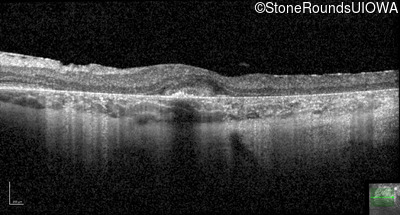
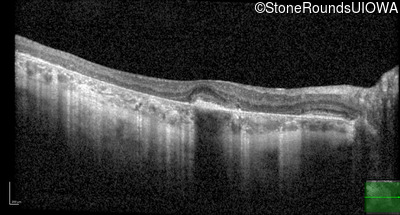
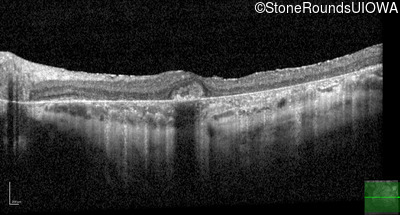

Case
SR290
Student Mode
Macular Disease (II)
Male
Male
Hidden
SR290
Student Mode
Macular Disease (II)
Male
Male
History
This 30 year old man first noticed poor vision in dim light when he was five years old. His visual acuity began to fall in his early 20's.
| Age at visit: 30 years |
| Age at visit: 34 years |
| Age at visit: 35 years |
| Age at visit: 37 years |
| Age at visit: 39 years |
| Age at visit: 40 years |
Diagnosis & molecular findings
| Disease | Gene | Allele 1 variant(s) | Allele 2 variant(s) | Inheritance mode |
|---|---|---|---|---|
| Macular Disease | WDR19 | His344Arg CAT>CGT | Ser485Ile AGT>ATT | AR |
Disease:
Gene:
Allele 1:
His344Arg CAT>CGT
Allele 2:
Ser485Ile AGT>ATT
Inheritance:
AR